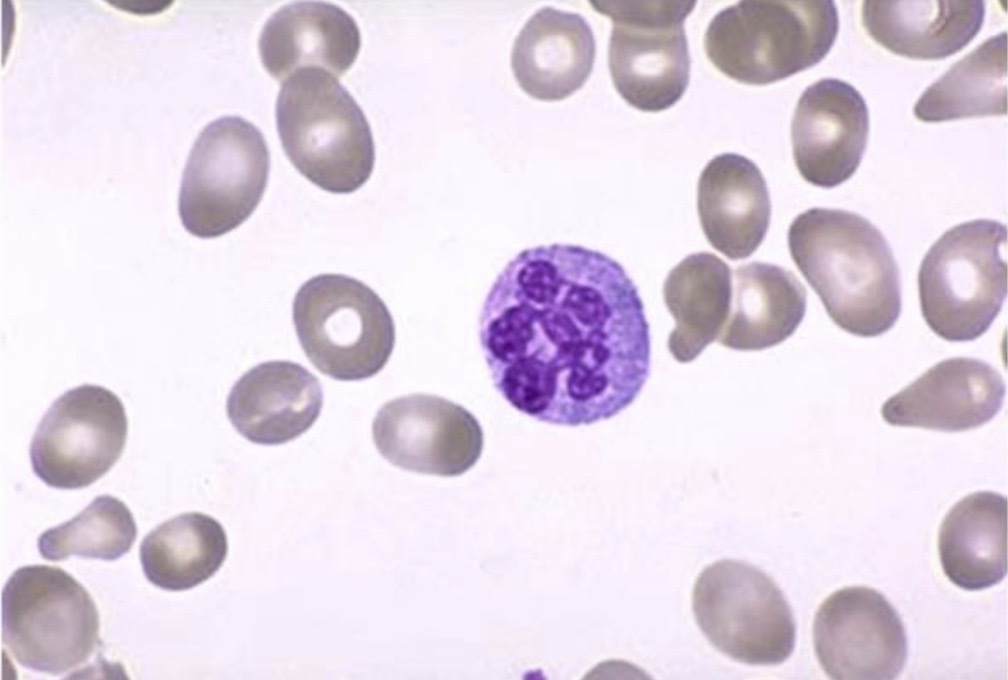

mention the stain used

perl stain / ferric ferrocyanide or prussian blue
MCV indicates
red cell volume or size
MCH indicates
mean Hb content
MCHC indicates
mean Hb concentration in red cells
RDW indicates
red cell distribution width
immature RBCs are called
Reticulocytes
what values seen in CBC are indicative of microcytic hypochromic anemia
Decreased MCV , MCH , MCHC
smear is indicative of which type of anaemia

microcytic hypochromic anemia
( iron def.)
what test will you order to confirm your diagnosis for iron def.
serum iron
Ferritin
transferrin saturation
serum ferritin
what will your Pts TIBC be incase of iron def. anemia
Increased
what will your Pts TIBC be incase of chronic disease anemia
Either normal or decreased
what will your Pts iron levels be incase of sideroblastic anemia
Increased
what will your Pts ferritin & transferrin saturation be incase of sideroblastic anemia
Increased
mention some common causes of iron def. anemia
- menstruation
- pregnancy , breastfeeding
- vegans
- child on high milk consumption
- peptic ulcer / celiac / IBD
etiology of sideroblastic anemia
Impaired heme synthesis
Genetic predisposition of sideroblastic anemia
x-linked
Autosomal dominant & recessive
Acquired sideroblastic anemia is due to
drugs / lead toxicity / myelodysplastic syndrome
what abnormalities are shown in the blood smear
- macrocytes
- ovalocytes
- hyper-segmented neutrophil
- macro-ovalocytes
serum folate levels in B12 def.
Either normal or increased
serum folate levels in folate def.
reduced
red cell folate levels in B12 def.
Either normal or reduced
red cell folate levels in folate def.
reduced


